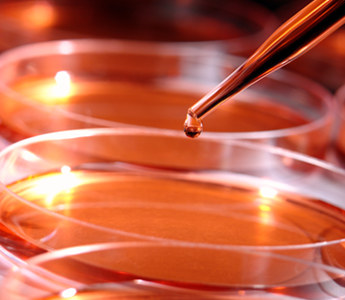
Liquid Handling liquid handling, liquid handler, liquid handling equipment, liquid handling systems, automated liquid handling

Pharmaceutical
From in silico to in vitro to in vivo to clinical trials, Tomtec has the laboratory automation solution to accelerate your time to discovery while controlling costs. For over 40 years Tomtec has been servicing big Pharma, Bio Pharma, Clinical and Research Laboratories with a wide range of rugged, well designed instruments that after 20+ years are still in service today. From our fourth generation automated pipetting workstation to the best in class cell harvester, Tomtec can fit your labs with instruments and world class support to accelerate your work-flows. Today our Quadra platform is the pipetting workstation of choice for oversee CROs. This makes the Quadra4 an ideal instrument for developing and transferring automated pipetting workflows worldwide.
For more information, contact us at info@tomtec.com